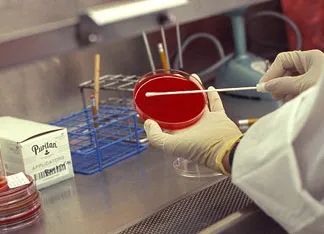

Tu médico recoge una muestra de tu faringe con un hisopo para hacer una prueba y descartar una infección. ¿Te preguntas qué pasa con tu muestra una vez recogida? Se manda “al laboratorio” para que se cultive, pero ¿qué quiere decir esto?. Este artículo te dará un paseo por el laboratorio donde se está procesando tu cultivo.
En el laboratorio, trabaja un equipo de profesionales que utiliza diferentes métodos para analizar tu muestra y deciden las pruebas que necesitan realizar en ella.
Para cada prueba, siempre se recoge la muestra más apropiada que proporcionará la mejor información para dicha prueba. Para aprender más respecto a otros tipos de muestras, además de la sangre o el frotis faríngeo, que se pueden recoger para la realización de pruebas analíticas, puede leer el artículo titulado obtención de muestras para pruebas de laboratorio.
Las etapas
Toma de la muestra para el cultivo
Un cultivo es una prueba que se utiliza con frecuencia para detectar las infecciones. Consiste en recoger una muestra de la zona de la infección e inocularla en un medio de cultivo (por ejemplo: agar, gelatina), para que crezca cualquier microorganismo presente, como bacterias u hongos.
Se pueden realizar cultivos de una amplia variedad de muestras de tu cuerpo, incluyendo la sangre, la orina, las heces, el esputo, y el pus de una herida. Los métodos de recogida de la muestra dependen del lugar de sospecha de la infección y del tipo de muestra que se recoge. El ejemplo de la imagen es la realización de un frotis faríngeo, que consiste en frotar con un hisopo en la parte posterior de la garganta para recoger la muestra para el cultivo.
.webp)
Etiquetado de la muestra del cultivo
Después de recoger la muestra de la garganta, el hisopo se introduce en un tubo de transporte para evitar la contaminación o que se seque, y el tubo de transporte se identifica con una etiqueta. En muchos laboratorios, la etiqueta puede ser preimpresa con el nombre del paciente y un número de identificación único para cada paciente o un código de barras con esta información.

Documentación
Después de etiquetar la muestra, se transporta al laboratorio donde se registra en el sistema informático del laboratorio. Cuando llega al laboratorio, sin importar su procedencia, se registra en el sistema informático del laboratorio. La etiqueta contiene toda la información necesaria para asegurar que los resultados de la prueba corresponden a la persona correcta. Habitualmente, en la solicitud escrita o electrónica que se envía con la muestra, consta el nombre y dirección del médico solicitante, además de la información del paciente, para que los resultados puedan ser enviados a la persona adecuada.

Preparación del cultivo
Una vez que la muestra llega al laboratorio, un técnico de laboratorio transfiere la muestra de la faringe que está en el hisopo a un medio de cultivo, como una placa de agar sangre, que permitirá el crecimiento de las bacterias. En la foto inferior, se observa como el hisopo se frota suavemente en la superficie del agar.
Incubación
La placa de agar etiquetada se coloca en el incubador, que es una cámara que mantiene una temperatura constante similar a la temperatura corporal y con un porcentaje específico de dióxido de carbono, que es óptimo para el crecimiento de las bacterias. El cultivo de la muestra de la faringe permanece en el incubador de 18 a 24 horas para permitir que cualquier bacteria presente tenga el tiempo suficiente para crecer.

Inspección del cultivo
Después de incubar la placa, el profesional del laboratorio examinará el cultivo. Algunas bacterias tienen un aspecto característico que le permite al profesional identificar presuntamente la bacteria específica, pero habitualmente se necesitan pruebas bioquímicas y serológicas para realizar la identificación correctamente. El profesional del laboratorio debe distinguir las bacterias potencialmente patógenas de la flora normal de la garganta que no producen daño, y por lo tanto no requieren un tratamiento posterior.

Pruebas para elegir el tratamiento
La causa bacteriana más frecuente de la infección de la garganta es una infección por el estreptococo del grupo A o Streptococcus pyogenes. Si se identifica esta bacteria en el frotis faríngeo, la persona infectada deberá ser tratada con antibióticos. Como el tratamiento antibiótico para el estreptococo ya está establecido, no se deben realizar más pruebas.
Sin embargo, algunos cultivos que son positivos para otras bacterias patógenas pueden requerir la realización de una prueba de susceptibilidad a los antibióticos, observando el crecimiento de la bacteria en presencia de un panel de antibióticos, para ver cuales son efectivos para tratar la infección. Como ejemplo de un método de susceptibilidad, se coloca una toma una muestra de la bacteria con un hisopo y se extiende en una placa de agar, colocando en ella posteriormente los discos impregnados de los diferentes antibióticos. Después de incubar la placa toda la noche, la ausencia de crecimiento de la bacteria alrededor de un disco nos indica la capacidad del antibiótico de inhibir el crecimiento de la bacteria. Los resultados de esta prueba le indican al médico claramente el antibiótico que debe recetar para curar la infección.

Informe del cultivo
Los resultados del cultivo quedan registrados en el sistema informático del laboratorio, dichos resultados se pueden enviar al médico que solicitó el cultivo por vía electrónica, copia escrita o por teléfono.

Enlaces
Artículos:
Interpretación del informe del laboratorio
Obtención de muestras para pruebas de laboratorio
En otras webs:
KidsHealth. Prueba estreptocócica: Cultivo de exudado faríngeo




